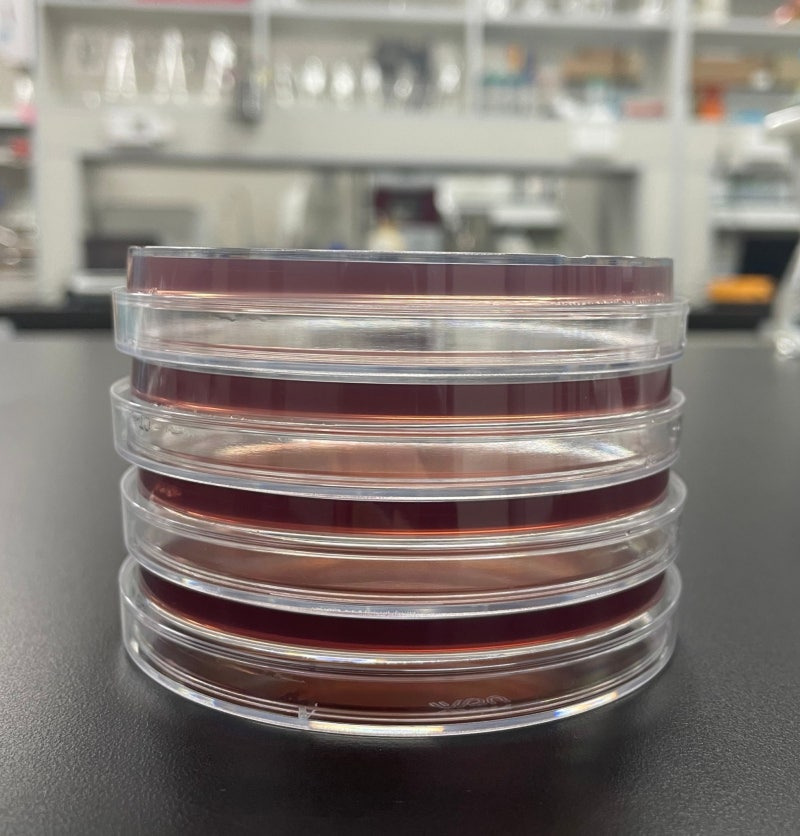
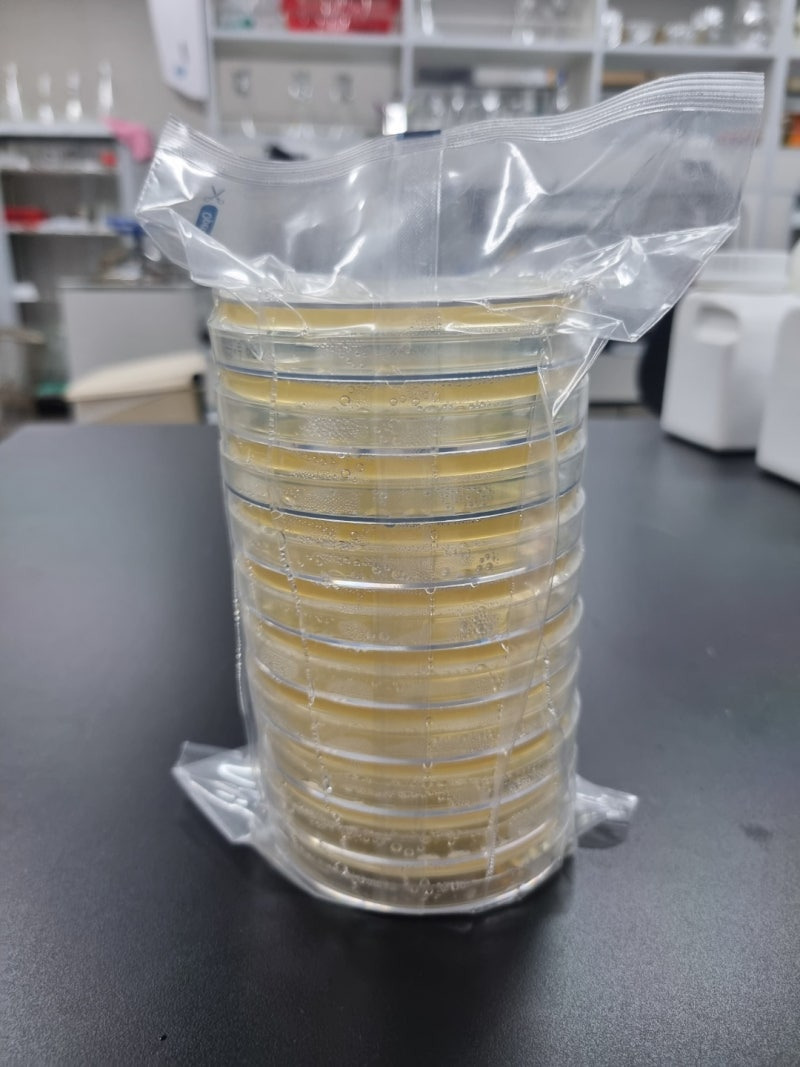

배지를 뒤집어서 배양하는 이유는 단순한 습관이 아니라, 실험 결과의 신뢰성과 재현성을 확보하기 위한 과학적 근거에 기반한다. 미생물 배양 과정은 작은 환경 변화에도 영향을 크게 받기 때문에, 배양기 내부의 온도·습도 조건을 안정적으로 유지하고 시료 간의 교차오염을 방지하는 것이 핵심이다.
배양 접시를 뚜껑이 위로 향한 상태로 두면, 배양기 내부의 열 순환으로 인해 수증기가 뚜껑 안쪽에 응결된다. 이 응결수가 물방울 형태로 떨어질 경우, 배지 위의 집락(colony)에 직접 닿아 퍼지게 된다. 집락이 번지면 형태가 불규칙해지고, 독립된 집락을 기준으로 하는 세균 수 계산(colony count)에 오류가 발생한다. 특히 항생제 내성 시험이나 미생물 동정 시험처럼 세밀한 형태 구분이 필요한 실험에서는 이러한 번짐 현상이 결과의 신뢰도를 심각하게 저하시킨다.
따라서 배지를 거꾸로 두면, 물방울이 배지 표면으로 떨어지지 않고 뚜껑 쪽에 머무르게 된다. 이 단순한 조치만으로도 응결수로 인한 번짐과 오염을 효과적으로 차단할 수 있다. 또한 배지를 뒤집어 배양할 경우, 배지 표면의 과도한 습기를 줄여 곰팡이류의 확산 속도를 억제하는 부수적 효과도 생긴다. 곰팡이는 높은 습도에서 빠르게 성장하기 때문에, 건조도가 일정하게 유지되는 환경은 세균 배양 실험에서 보다 안정적인 결과를 만든다.
교차오염 방지 측면에서도 뒤집기 배양은 유리하다. 응결수가 여러 집락 위로 떨어질 경우 서로 다른 미생물이 섞이는 교차오염(cross contamination)이 발생할 수 있는데, 이는 미생물의 순수 분리(pure culture)를 근본적으로 방해한다. 반대로 뒤집은 상태에서는 이런 물리적 혼합이 일어나기 어렵다. 결과적으로 각 집락이 독립적으로 성장하여 형태적 관찰과 계수가 명확해진다.
보관 효율성 또한 중요한 이유 중 하나다. 뒤집어 두면 배지 표면의 수분 증발이 서서히 진행되어 탈수나 갈라짐이 늦춰진다. 장기 배양이나 대량 실험 시, 배지를 여러 층으로 쌓아둘 때에도 뒤집어 두는 것이 안정적이다. 물방울이 아래쪽 접시로 흘러들지 않아 접시들이 서로 달라붙지 않고, 실험자 간의 시료 혼동을 방지할 수 있다.
역사적으로 보면, 배양기술의 발전과 함께 뒤집기 배양은 하나의 표준으로 자리 잡았다. 1887년 Julius Richard Petri가 덮개가 있는 배양접시를 고안했을 당시에는 단순히 외부 오염을 막는 것이 목적이었다. 그러나 이후 연구자들이 실험 중 응결수 문제로 인한 번짐 현상을 발견하면서, 접시를 뒤집어 두는 방식이 더 안정적이라는 사실이 경험적으로 입증되었다. 그 결과 현재는 전 세계 미생물 실험실에서 ‘배지는 뒤집어 배양한다’는 규칙이 거의 불문율로 통용되고 있다.
다만 배양이 완료된 후 결과를 관찰할 때는 다시 원래 방향으로 돌려야 한다. 그래야 집락의 색상, 형태, 크기 등 미세한 구조를 정확히 관찰할 수 있기 때문이다. 배양 중에는 물방울 방지와 오염 예방이 중요하지만, 관찰 단계에서는 시각적 판단이 우선되므로 방향을 되돌리는 것이 합리적이다.
결론적으로 배지를 뒤집어서 배양하는 이유는 응결수 방지와 오염 방지라는 두 가지 근본 원칙으로 요약된다. 이 단순한 행동 하나가 세균의 독립적 성장을 보장하고, 실험의 재현성과 정확도를 높이는 결정적 역할을 한다.


2025.06.03 - [COFFEEPHARM QCLAB ] - About Us
About Us
커피 한 잔에도 믿음이 필요하다고 느낀 적 있는가. 예쁜 카페, 감성적인 분위기, 고급 원두라는 말은 흔하다. 하지만 정말 이 커피가 어디서, 어떻게 만들어졌고, 내가 마신 이 맛이 다음에 와도
qclab.kr
'품질관리(Quality Control) > 미생물' 카테고리의 다른 글
| 무균시험법(Sterility Test)에 사용되는 주요 배지와 세정액 (1) | 2025.10.20 |
|---|---|
| 무균시험(Sterility Test)-유럽약전(EP), 일본약전(JP), 미국약전(USP) 공정서 스캔본 공유 (1) | 2025.10.20 |
| 제약회사 품질관리 무균시험법의 모든 것: 원리부터 판정까지 완벽 해설 (1) | 2025.10.16 |
| 무균 제조 환경 관리의 중요성 (1) | 2025.09.04 |
| 엘라이자(ELISA) 원리와 실험 방법: 항원·항체 반응을 활용한 정밀 분석 기법 feat.제약 품질관리 노트 (13) | 2025.08.21 |